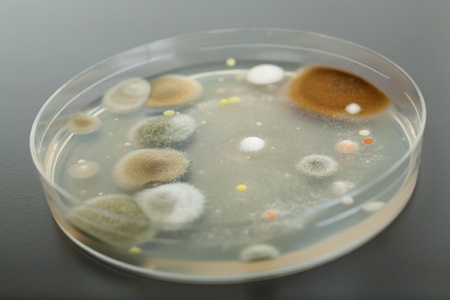
petri dish with agar and bacterium colony on grey table topの写真素材

写真素材 - petri dish with agar and bacterium colony on grey table top
キーワード
- analysis
- analyzing
- bacteria
- bacterium
- biological
- biology
- biotechnology
- brown
- cells
- chemical
- chemistry
- clinical
- culture
- diagnostics
- disease
- dish
- experiment
- fluid
- grey
- health
- healthcare
- holding
- hygiene
- infection
- instrument
- jelly
- lab
- laboratory
- medical
- medicine
- microbiology
- orange
- organism
- petri
- pharmacology
- pink
- poisonous
- protective
- research
- sample
- science
- sickness
- virus
- yellow
- agar
類似作品
close-up of col...
detail of bacte...
Backgrounds of ...
Bacillus sp. on...
close-up of sci...
Backgrounds of ...
Colony of bacte...
Colonies of dif...
close-up of vib...
Bacteria growin...
Close up of bac...
microbial cultu...
Backgrounds of ...
Bacterial cultu...
Backgrounds of ...
Bacterial colon...
Bacterial cultu...
Close-up detail...
Close up of bac...
Bacteria growin...
bacterial colon...
Laboratory petr...
Colony of blue ...
Green mold grow...
top view of a p...
Colony characte...
Bacteria and vi...
Backgrounds of ...
bacteria colony...
abstract air bu...
bacteria colony...
Plant Petri on ...
bacteria colony...
Petri Dish with...
Backgrounds of ...
microbial cultu...
3d rendering of...
petri dish with...
Colorful microb...
Petri dish with...
Petri dish with...
A macro shot fr...
This image show...
Petri dishes fo...
petri dish fill...
Different bacte...
Bacteria in a p...
Backgrounds of ...
3d illustration...